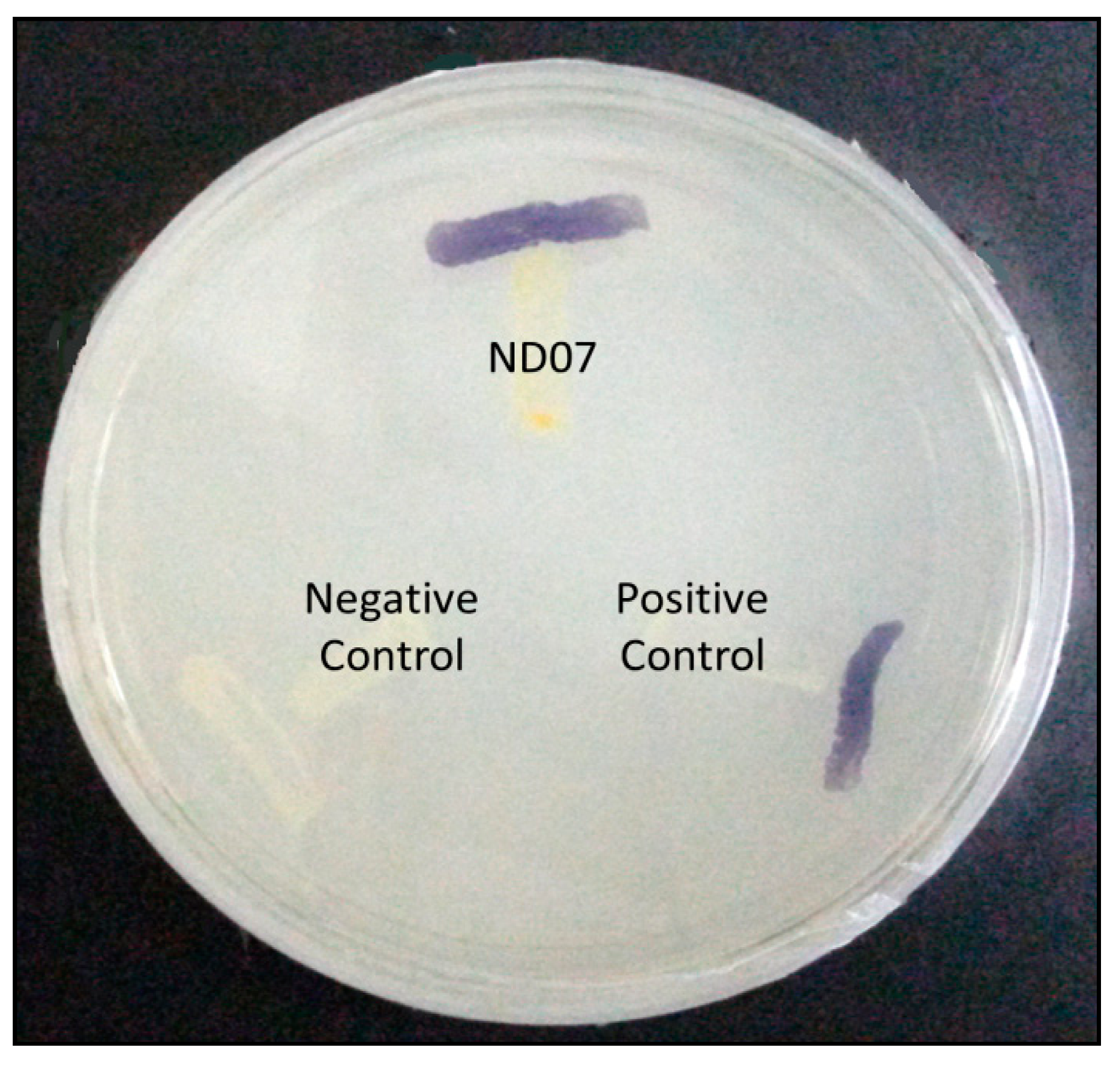
Sensors 14 11595f2 1024

Pseudomonas cremoricolorata Strain ND07 Produces N-acyl Homoserine Lactones as Quorum Sensing Molecules
Abstract
: Quorum sensing (QS) is a bacterial cell-to-cell communication system controlling QS-mediated genes which is synchronized with the population density. The regulation of specific gene activity is dependent on the signaling molecules produced, namely N-acyl homoserine lactones (AHLs). We report here the identification and characterization of AHLs produced by bacterial strain ND07 isolated from a Malaysian fresh water sample. Molecular identification showed that strain ND07 is clustered closely to Pseudomonas cremoricolorata. Spent culture supernatant extract of P. cremoricolorata strain ND07 activated the AHL biosensor Chromobacterium violaceum CV026. Using high resolution triple quadrupole liquid chromatography-mass spectrometry, it was confirmed that P. cremoricolorata strain ND07 produced N-octanoyl-l-homoserine lactone (C8-HSL) and N-decanoyl-l-homoserine lactone (C10-HSL). To the best of our knowledge, this is the first documentation on the production of C10-HSL in P. cremoricolorata strain ND07.1. Introduction
Quorum sensing (QS) is a term coiled by Fuqua and co-workers referring to a bacterial cell-to-cell communication system used as a tool to control their physiological processes [1]. The regulation of specific activity is dependent on the concentration of the cell population which is synchronized by the signaling molecules produced. Virulence factors are known to be the best-documented activity regulated by QS [2,3]. The signaling molecules responsible for the QS action is known as autoinducers which are classified into two major groups, the autoinducer-1 group such as the N-acyl homoserine lactones (AHLs) which are commonly utilized by Gram-negative bacteria, and oligopeptides classified as autoinducer-2, utilized by Gram-positive bacteria [4,5].
To date, the most commonly studied autoinducers are the AHL molecules produced by most Gram-negative bacteria. The AHL molecule side chain length varies from short chain (C4) to long chain (C18) carbon chains [6]. When at a higher population size, AHLs accumulate and bind to the AHL receptor protein forming the AHL-receptor complex which is then an active regulator that regulates QS-dependent genes. This QS system involves the LuxI-LuxR complexes where LuxI is AHL synthase and LuxR is the AHL receptor protein [7,8]. Once the production of AHL has exceeded the threshold level, the AHL/LuxR complex will then be in an active form and be able to regulate QS genes. This will then allow the QS bacteria to synchronize the gene regulation in a cell density-dependent manner allowing group behaviors in unison. This will give QS bacteria a competitive advantage allowing them to overcome many challenges, which is impossible for a few cells but easy with a population of cells.
QS bacteria have been isolated mainly from clinical and some other habitats [4,5] while there is still not much work done on the QS properties of fresh water-borne bacteria. Other than that, the study of QS could be beneficial in biotechnology whereby QS-based engineered genetic devices could perform a wide array of functions such as controlling gene expression, population and maintenance of synthetic ecosystems [9]. The knowledge about QS could have an impact in regulating bacterial phenotypes thus inhibition of QS represents a strategy which has also been applied to, for example, engineered plants which results in plants more resistant to infection by common pathogens such as Pseudomonas syringae and Erwinia carotovora [9,10]. Fresh water could be a potential environmental reservoir for various bacteria [11] and hence it raised our interest in isolating bacteria that possess QS properties from fresh water. It is the aim of this study to acquire isolates, and study the AHL production by Pseudomonas cremoricolorata strain ND07.
2. Experimental Section
2.1. Collection of Water Samples
The collection site of water samples was at the Sungai Ampang waterfalls, Malaysia (GPS coordinate: N 03°12.69′ E 101°47.72′) in 2013. Water samples were collected at the depth of 12–17 cm using sterilized plastic tubes. The temperatures and pH of the samples were recorded. Water samples were kept in an icebox and brought to the laboratory for further analysis [12].
2.2. Isolation of Bacterial Strains
Overnight culture was serially diluted and plated on Reasoner's 2A (R2A) agar [13]. The plates were incubated at 28 °C for 24 h. After 24 h, any visibly distinct bacterial colonies were identified and each colony was transferred by streaking onto Trypticase Soy Agar (TSA) followed by incubation (28 °C for 24 h). The color, shape and size as well as other visual properties of the colonies were recorded.
2.3. Strain Identification Using 16S rDNA
The QIAamp® DNA Mini Kit (Qiagen, Germantown, MD, USA) was used to extract and purify bacterial genomic DNA of strain ND07 and the resulting DNA was used as template for PCR. The forward primer 27F and the reverse primer 1525R were used to amplify the 16S rDNA gene [14]. The PCR condition used in this study was as previously reported [15]. GenBank databases using the BLASTN program were used to compare gene sequences followed by sequence alignment and phylogenetic analyses using the Molecular Evolutionary Genetic Analysis (MEGA) version 6 [14].
2.4. Detection of AHL
An AHL biosensor, namely Chromobacterium violaceum CV026, was used to detect the presence of short chain AHLs [16] whereby CV026 cells will respond by forming a purple pigmentation [14,16] on Luria Bertani (LB) agar. Erwinia carotovora GS101 were used as positive control while Erwinia carotovora PNP22 was negative control [17,18].
2.5. Extraction of AHLs
The bacterial colony of strain ND07 showing positive results for the detection of AHL was grown overnight in LB broth buffered to pH 6.5 with 3-(N-morpholino)propanesulfonic acid (MOPS, 50 mM, pH 6.5) at 28 °C with shaking (220 rpm). An equal volume of acidified (0.1% v/v acetate acid) ethyl acetate was used to extract twice the spent supernatant [19]. The AHL extracts were then dried in a fumehood and stored at −20 °C for further analysis using liquid chromatography-mass spectrometry.
2.6. AHL Identification by Triple Quadrupole Liquid Chromatography Mass Spectrometry (LC/MS)
Extracted AHLs were resuspended in acetonitrile followed by LC/MS analysis using an Agilent 1290 Infinity LC system (Agilent Technologies, Santa Clara, CA, USA) equipped with an Agilent ZORBAX Rapid Resolution High Definition SB-C18 Threaded Column [20]. Mass spectrometry parameters and mobile phases used were essentially performed according to a reported method [20]. Precursor ion-scanning analysis were performed in positive ion mode with Q3 set to monitor for m/z 102 and Q1 set to scan a mass range of m/z 80 to 400. A molecular mass of m/z 102 is characteristic of the lactone ring moiety thus indicating presence of AHLs. The Agilent Mass Hunter software was used to analyse the MS data in order to confirm the presence of AHLs [20]. Analysis was based on the retention index and the comparison of the EI mass spectra with AHL standards was carried out.
2.7. Biofilm Assay
The biofilm assay was performed as described previously [21,22]. Briefly, the overnight culture of strain ND07 was adjusted to OD600 of 0.1, and the diluted culture was added with LB medium supplemented with catechin (1 mg/mL, anti-QS compound) [1] in a microtitre well. ND07 cultures treated with and without DMSO served as negative and positive controls, respectively. The ND07 cells with different culture conditions were incubated statically for 36 h at 28 °C. The planktonic bacteria were removed by washing thrice with sterile distilled water [3] and the plate was air-dried for 15 min followed by staining with 200 μL of 0.1% (w/v) crystal violet for 30 min. After staining, the excess crystal violet was removed and washed with sterile distilled water twice. The quantitative analysis of biofilm production was done by adding 200 μL of 95% (v/v) ethanol and 100 μL of the resulting solution was transferred to a new microtitre plate. The absorbance of the solution was read at OD590 with microplate reader. All experiments were performed in triplicate.
3. Results and Discussion
3.1. Identification of Bacteria Isolates
A pure colony of strain ND07 was obtained after several successive streakings. Physically the strain ND07 colonies were smooth, entire, flat to convex and creamy yellow in color. Strain ND07 was identified using 16S rDNA gene nucleotide analysis, which showed 99% similarity to Pseudomonas cremoricolorata strain IAM 1541. The result obtained was based on a web search and phylogenetic analysis of 16S rDNA nucleotide sequence (Figure 1). A total of 975 positions in the final dataset was used for analysis (Figure 1). All the characteristics of Pseudomonas cremoricolorata are in agreement with the reported work by Uchino and colleagues [23].
3.2. Detection of AHLs
Pseudomonads are ubiquitous Gram-negative bacteria which live in several environmental niches and have the ability to undergo transitions to become dangerous human pathogens [24]. Many Pseudomonads play roles as plant pathogens and also as opportunistic human pathogens [25]. According to Whiteley and colleagues, P. aeruginosa produces two different AHLs known as 3-oxo-C12-HSL and C4-HSL. Other members of the Pseudomonads, such as P. syringae produce 3-oxo-C6-HSL [26], P. chlororaphis produces C6-HSL [27] and P. fluorescens produces long chain AHLs [28].
P. cremoricolorata strain ND07 was screened for the production of AHLs by using C. violaceum CV026. Strain ND07 showed positive results by triggering violacein production in C. violaceum CV026, suggesting the production of short chain AHLs (Figure 2). To further verify the AHL production, we used high resolution triple quadrupole LC/MS. The presence of AHLs were confirmed by the mass spectrometry analysis, and specifically N-octanoyl-l-homoserine lactone (C8-HSL) (m/z 228.2000) and N-decanoyl-l-homoserine lactone (C10-HSL) (m/z 256.5000) were detected (Figure 3).
The MS results shown in Figure 3 confirmed the presence of C8-HSL and C10-HSL in the extract of spent culture supernatant of P. cremoricolorata strain ND07, which is the first report of such a finding. According to Uchino and colleagues, P. cremoricolorata sp. nov. has been identified as a new species [23]. Our work on P. cremoricolorata will pave a way to a deeper understanding of the QS system in this bacterium.
3.3. Biofilm Formation of Enterobacter sp. Strain ND07
Biofilm formation is often a QS-regulated phenotype [29,30]. The formation of biofilms often initiates with bacteria colonization, followed by surface attachment and finally biofilm development and maturation. The ability to form bacterial biofilms is often linked to pathogenic traits during chronic infections. There are several reports that members of Pseudomonas possess the ability to form biofilms [31]. P. cremoricolorata strain ND07 has been shown to be able to form biofilms (Figure 4). In our study, we demonstrated that the biofilm formation by strain ND07 can be interrupted by catechin, an anti-QS compound [21] and this suggests that biofilm formation by strain ND07 could be a QS-dependent phenotype in P. cremoricolorata strain ND07 (Figure 4).
Since QS regulates a battery of bacterial virulence factors [32], hence this work illustrated the significance in expanding the research on AHL-producing bacteria present in environmental samples. We are currently conducting whole genome sequencing on P. cremoricolorata strain ND07 aiming to study the AHL synthase and receptor genes that will provide more insight into the QS regulatory system in this bacterium.
4. Conclusions/Outlook
In conclusion, P. cremoricolorata strain ND07 showed QS activity with the production of C8-HSL and C10-HSL according to LC/MS analysis. To the best of our knowledge, this is the first report of such a finding. P. cremoricolorata, ND07 has also been shown to form biofilms which could be inhibited by anti-QS compounds, suggesting that it is QS-dependent trait. Our group is currently performing whole genome sequencing in order to identify the luxI/luxR genes in this isolate.
Acknowledgments
This work was supported financially by the University of Malaya via High Impact Research Grant (UM-MOHE HIR Grant UM.C/625/1/HIR/MOHE/CHAN/14/1, no. H-50001-A000027). Kok-Gan Chan graciously acknowledges the support of this funding.
Author Contributions
Nina Yusrina Muhamad Yunos, Wen-Si Tan, Nur Izzati Mohamad, Pui-Wan Tan, Tan-Guan-Sheng Adrian, Wai-Fong Yin carried out the experiments. Kok-Gan Chan and Wai-Fong Yin analysed the data. Chong-Lek Koh and Choon-Kook Sam proofread and corrected the manuscript and all authors approved the final draft. Kok-Gan Chan supervised the project and obtained the funding.
Conflicts of Interest
The authors declare no conflict of interest.
References
- Ferkinghoff-Bong, J.; Sams, T. Size of quorum sensing communities. Mol. BioSyst. 2014, 10, 103–109. [Google Scholar]
- Winzer, K.; Hardie, K.R.; Williams, P. Bacterial cell-to-cell communication: Sorry, can't talk now—Gone to lunch. Curr. Opin. Microbiol. 2002, 5, 216–222. [Google Scholar]
- Williams, P.; Winzer, K.; Chan, W.C.; Camara, M. Look who's talking: Communication and quorum sensing in the bacterial world. Philos. Trans. R. Soc. B 2007, 362, 1119–1134. [Google Scholar]
- Chen, J.W.; Gan, H.M.; Yin, W.F.; Chan, K.G. Genome sequence of Roseomonas sp. strain B5, a quorum quenching N-acyl homoserine lactone-degrading bacterium isolated from Malaysian tropical soil. J. Bacteriol. 2012, 194, 6681–6682. [Google Scholar]
- Bassler, B.L. How bacteria talk to each other: Regulation of gene expression by quorum sensing. Curr. Opin. Microbiol. 1999, 2, 582–587. [Google Scholar]
- Bandara, H.M.H.N.; Lam, O.L.T.; Jin, L.J.; Samaranayake, L. Microbial chemical signaling: A current perspective. Crit. Rev. Microbiol. 2012, 38, 217–249. [Google Scholar]
- Tan, L.Y.; Yin, W.F.; Chan, K.G. Silencing quorum sensing through extracts of Melicope lunu-ankenda. Sensors 2012, 12, 4339–4351. [Google Scholar]
- Deep, A.; Chaudhary, U.; Gupta, V. Quorum sensing and bacterial pathogenicity: From molecules to disease. J. Lab. Physicians 2011, 3, 4–11. [Google Scholar]
- Choudhary, S.; Schmidt-Dannert, C. Applications of quorum sensing in biotechnology. Appl. Microbiol. Biotechnol. 2010, 86, 1267–1279. [Google Scholar]
- Teiber, J.F.; Horke, S.; Haines, D.C.; Chowdhary, P.K.; Xiao, J.; Kramer, G.L.; Haley, R.W.; Draganov, D.I. Dominant role of paraoxonases in inactivation of the Pseudomonas aeruginosa quorum-sensing signal N-(3-oxododecanoyl)-l-homoserine lactone. Infect. Immun. 2008, 76, 2512–2519. [Google Scholar]
- Stewart, P.S.; Davison, W.M.; Steenbergen, J.N. Daptomycin rapidly penetrates a Staphylococcus epidermidis biofilm. Antimicrob. Agents Chemother. 2009, 53, 3505–3507. [Google Scholar]
- Yunos, N.Y.M.; Tan, W.S.; Mohamad, N.I.; Tan, P.W.; Adrian, T.G.S.; Yin, W.F.; Chan, K.G. Discovery of Pantoea rodasii strain ND03 that produces N-(3-oxo-hexanoyl)-l-homoserine lactone. Sensors 2014, 14, 9145–9152. [Google Scholar]
- Stetzenbach, L.D.; Kelley, L.M.; Sinclair, N.A. Isolation, identification and growth of well-water bacteria. Groundwater 1986, 24, 6–10. [Google Scholar]
- Chen, J.W.; Koh, C.L.; Sam, C.K.; Yin, W.F.; Chan, K.G. Short chain N-acyl homoserine lactone production by soil isolate Burkholderia sp. strain A9. Sensors 2013, 13, 13217–13227. [Google Scholar]
- Wong, C.S.; Koh, C.L.; Sam, C.K.; Chen, J.W.; Chong, Y.M.; Yin, W.F.; Chan, K.G. Degradation of bacterial quorum sensing signalling molecules by the microscopic yeast Trichosporon Loubieri isolated from tropical wetland waters. Sensors 2013, 13, 12943–12957. [Google Scholar]
- McClean, K.H.; Winson, M.K.; Fish, L.; Taylor, A.; Chhabra, S.R.; Camara, M.; Daykin, M.; Lamb, J.H.; Swift, S.; Bycroft, B.W.; et al. Quorum sensing and Chromobacterium violaceum: Exploitation of violacein production and inhibition for the detection of N-acylhomoserine lactones. Microbiology 1997, 143, 3703–3711. [Google Scholar]
- Lau, Y.Y.; Sulaiman, J.; Chen, J.W.; Yin, W.F.; Chan, K.G. Quorum sensing activity of Enterobacter asburiae isolated from lettuce leaves. Sensors 2013, 13, 14189–14199. [Google Scholar]
- McGowan, S.; Sebaihia, M.; Jones, S.; Yu, B.; Bainton, N.; Chan, P.F.; Bycroft, B.; Stewart, G.S.A.B.; Williams, P.; Salmond, G.P.C.; et al. Carbapenem antibiotic production in Erwinia carotovora is regulated by CarR, a homologue of the LuxR transcriptional activator. Microbiology 1995, 141, 541–550. [Google Scholar]
- Zhu, H.; Thuruthyil, S.J.; Willcox, M.D.P. Determination of quorum-sensing signal molecules and virulence factors of Pseudomonas aeruginosa isolates from contact lens-induced microbial keratitis. J. Med. Microbiol. 2002, 51, 1063–1070. [Google Scholar]
- Yin, W.F.; Purmal, K.; Chin, S.; Chan, X.Y.; Koh, K.L.; Sam, C.K.; Chan, K.G. N-acyl homoserine lactone production by Klebsiella pneumoniae isolated from human tongue surface. Sensors 2012, 12, 3472–3483. [Google Scholar]
- Vandeputte, O.M.; Kiendrebeogo, M.; Rajaonson, S.; Diallo, B.; Mol, A.; El Jaziri, M.; Baucher, M. Identification of catechin as one of the flavonoids from Combretum albiflorum bark extract that reduces the production of quorum-sensing-controlled virulence factors in Pseudomonas aeruginosa PAO1. Appl. Environ. Microbiol. 2010, 76, 243–253. [Google Scholar]
- Tan, W.S.; Muhamad Yunos, N.Y.; Tan, P.W.; Mohamad, N.I.; Adrian, T.G.S.; Yin, W.F.; Chan, K.G. Freshwater-borne bacteria isolated from a Malaysian rainforest waterfall exhibiting quorum sensing properties. Sensors 2014, 14, 10527–10537. [Google Scholar]
- Uchino, M.; Shida, O.; Uchimura, T.; Komagata, K. Recharacterization of Pseudomonas fulva Iizuka and Komagata 1963, and proposals of Pseudomonas parafulva sp. nov. and Pseudomonas cremoricolorata sp. nov. J. Gen. Appl. Microbiol. 2011, 47, 247–261. [Google Scholar]
- Venturi, V. Regulation of quorum sensing in Pseudomonas. FEMS Microbiol. Rev. 2006, 30, 274–291. [Google Scholar]
- Whiteley, M.; Lee, K.M.; Greenberg, E.P. Identification of genes controlled by quorum sensing in Pseudomonas aeruginosa. Proc. Natl. Acad. Sci. USA 1999, 96, 13904–13909. [Google Scholar]
- Dumenyo, C.K.; Mukherjee, A.; Chun, W.; Chatterjee, A.K. Genetic and physiological evidence for the production of N-acyl homoserine lactones by Pseudomonas syringae pb. syringae and other fluorescent plant pathogenic Pseudoonas species. Eur. J. Plant Pathol. 1998, 104, 569–582. [Google Scholar]
- Chin, A.W.T.F.; van den Broek, D.; Lugtenberg, B.J.; Bloemberg, G.V. The Pseudomonas chlororaphis PCL1391 sigma regulator psrA represses the production of the antifungal metabolites phenazine-1-carboxamide. Mol. Plant Microbe Interact. 2005, 18, 244–253. [Google Scholar]
- El-Sayed, A.K.; Hothersall, J.; Thomas, C.M. Quorum-sensing-dependent regulation of biosynthesis of the polyketide antibiotic mupirocin in Pseudomonas fluorescens NCIMB 10586. Microbiology 2001, 147, 2127–2139. [Google Scholar]
- Lade, H.; Paul, D.; Kweon, J.H. Isolation and molecular characterization of biofouling bacteria and profiling of quorum sensing signal molecules from membrane bioreactor activated sludge. Int. J. Mol. Sci. 2014, 15, 2255–2273. [Google Scholar]
- Chong, Y.M.; Yin, W.F.; Ho, C.Y.; Mustafa, M.R.; Hadi, A.H.A.; Awang, K.; Narrima, P.; Koh, C.L.; Appleton, D.R.; Chan, K.G.; et al. Malabaricone C from Myristica cinnamomea exhibits anti-quorum sensing activity. J. Nat. Prod. 2011, 74, 2261–2264. [Google Scholar]
- Drenkard, E.; Ausubel, F.M. Pseudomonas biofilm formation and antibiotic resistance are linked to phenotypic variation. Nature 2002, 18, 740–743. [Google Scholar]
- Krishnan, T.; Yin, W.F.; Chan, K.G. Inhibition of quorum sensing-controlled virulence factor production in Pseudomonas aeruginosa PAO1 by Ayurveda spice clove (Syzgium Aromaticum) bud extract. Sensors 2012, 12, 4016–4030. [Google Scholar]

© 2014 by the authors; licensee MDPI, Basel, Switzerland. This article is an open access article distributed under the terms and conditions of the Creative Commons Attribution license ( http://creativecommons.org/licenses/by/3.0/).
Share and Cite
Yunos, N.Y.M.; Tan, W.-S.; Koh, C.-L.; Sam, C.-K.; Mohamad, N.I.; Tan, P.-W.; Adrian, T.-G.-S.; Yin, W.-F.; Chan, K.-G. Pseudomonas cremoricolorata Strain ND07 Produces N-acyl Homoserine Lactones as Quorum Sensing Molecules. Sensors 2014, 14, 11595-11604. https://doi.org/10.3390/s140711595
Yunos NYM, Tan W-S, Koh C-L, Sam C-K, Mohamad NI, Tan P-W, Adrian T-G-S, Yin W-F, Chan K-G. Pseudomonas cremoricolorata Strain ND07 Produces N-acyl Homoserine Lactones as Quorum Sensing Molecules. Sensors. 2014; 14(7):11595-11604. https://doi.org/10.3390/s140711595
Chicago/Turabian StyleYunos, Nina Yusrina Muhamad, Wen-Si Tan, Chong-Lek Koh, Choon-Kook Sam, Nur Izzati Mohamad, Pui-Wan Tan, Tan-Guan-Sheng Adrian, Wai-Fong Yin, and Kok-Gan Chan. 2014. "Pseudomonas cremoricolorata Strain ND07 Produces N-acyl Homoserine Lactones as Quorum Sensing Molecules" Sensors 14, no. 7: 11595-11604. https://doi.org/10.3390/s140711595
APA StyleYunos, N. Y. M., Tan, W.-S., Koh, C.-L., Sam, C.-K., Mohamad, N. I., Tan, P.-W., Adrian, T.-G.-S., Yin, W.-F., & Chan, K.-G. (2014). Pseudomonas cremoricolorata Strain ND07 Produces N-acyl Homoserine Lactones as Quorum Sensing Molecules. Sensors, 14(7), 11595-11604. https://doi.org/10.3390/s140711595

